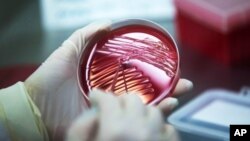

Гражданин Китая Ван Юньбинь выздоровел после заражения коронавирусом и выписан из краевой инфекционной больницы в Забайкалье. Информацию о выздоровлении пациента подтвердили в Ситуационном центре Забайкальского края, сообщает ТАСС.
Ван Юньбинь стал вторым пациентом с коронавирусом в России, выписанным из больницы. Накануне была выписана китайская студентка, обучавшаяся в Тюмени. Она, по словам медиков, полностью здорова.
Жена и дочь Вана останутся в инфекционной больнице на карантине. Их должны отпустить в конце этой недели, когда медики проведут ещё один тест на коронавирус. Сам же Ван, утверждают врачи, здоров и не заразен.
В больницу Ван Юньбинь попал ещё 26 января, но правильный диагноз – заражение коронавирусом нового типа – ему поставили не сразу. Первые тесты показали отрицательный результат и он в течение пяти дней свободно передвигался по Чите. Лишь после повторного обращения к медикам Ван Юньбиня госпитализировали. Он жаловался на условия в российской больнице, которые улучшились после того, как его прямо в палате навестил министр здравоохранения Забайкалья Валерий Кожевников в противочумном костюме.
Накануне появились сообщения о побеге из Боткинской больницы в Санкт-Петербурге пациентки, помещённой в карантин. Главный врач больницы обратился с заявлением в полицию. Как рассказала Алла Ильина журналистам, она прилетела из Китая в конце января. В Пулково ей посоветовали при малейших проблемах со здоровьем обращаться к врачам. 4 февраля у неё заболело горло, и после вызова скорой к ней явилась комиссия из Роспотребнадзора. У неё взяли анализы и направили на 14-дневный карантин. Хотя изначально обещали, что он продлится один день. Ильина посчитала, что её свободу ограничили незаконно и сбежала из карантинного бокса, взломав замок.
В мире коронавирус нового типа распространился уже в 50 странах, его жертвами стали более 1100 человек. Общее количество заразившихся составляет свыше 45 тысяч человек. Подавляющее большинство случаев заболевания и гибели людей – по-прежнему в китайской провинции Хубэй.
Всемирная организация здравоохранения признала вспышку коронавируса чрезвычайной ситуацией.
Из-за вируса закрыта российско-китайская граница на Дальнем Востоке, приостановлено пассажирское сообщение с Китаем. С 4 февраля ограничен въезд иностранцев из КНР. С 14 февраля будет введен запрет на чартерные рейсы между Россией и Китаем.